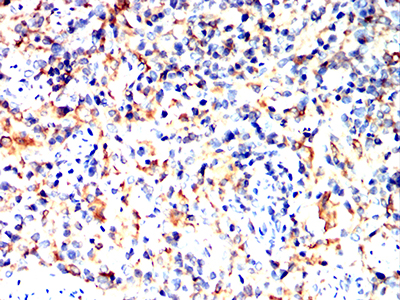

CD Antibodies
Products
Products
Mouse Monoclonal Antibody to CD163
All
ELISA
WB
FCM
IHC
- Catalog: TD-31803
- Clonality: mAb
- Application: WB, IHC, FCM
- Synonyms: M130; MM130; SCARI1
-
Specification:
100ul 50ul
-
Prices:
¥2180